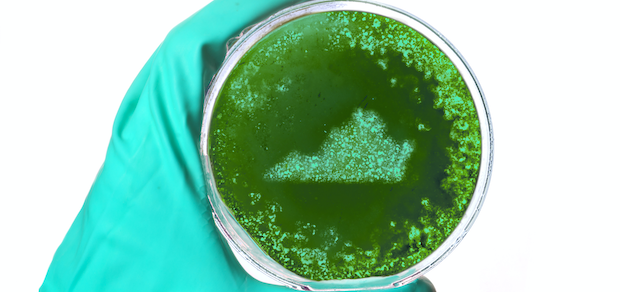
Virginia sports betting

Legal Sports Betting
Legal Sports Betting issues and which USA States allow online and land gambling venues.
Sports Betting, Online Casino ‘Signed Before Christmas’

Michigan residents may have an unexpected present under the tree this Christmas. State Sen. Curtis Hertel Jr. tells Legal Sports Report that negotiations between stakeholders and Gov. Gretchen Whitmer to work out the details on sports betting and internet gambling bills are nearly complete. “Negotiations are going well,” Hertel said. “I fully expect the bills […]
read moreNFL Player Suspended Through 2020 Season For Betting On Games

The NFL announced that a member of the Arizona Cardinals has been suspended through the 2020 season after betting on league games “on multiple occasions this season.” While offering few details, the NFL said no game was compromised because of wagering by defensive back Josh Shaw. Shaw is currently on the Cardinals’ injured reserve. League […]
read moreVirginia Sports Betting Could Generate $400M In Mobile Revenue
A legislative study suggests mobile sports betting revenue in Virginia could approach $400 million at maturity in 2028. The study, conducted by The Innovation Group and Regulatory Management Counselors in conjunction with the Joint Legislative Audit and Review Commission, looked at multiple scenarios for Virginia sports betting. Per the study, a completely open market with […]
read moreState Horse Racing Industry Backs Tribal California Sports Betting Effort

The California horse racing industry was pleasantly surprised by the proposed ballot initiative to legalize sports betting that was filed recently by Indian tribal chairmen. Robyn Black, a longtime lobbyist for the California Thoroughbred Breeders Association, tells Legal Sports Report the racetrack industry wasn’t involved in the drafting of the California Legalize Sports Betting on American […]
read moreOnce More Into The Breach For Kentucky Sports Betting Effort

A familiar name plans to take another shot at legalizing Kentucky sports betting in 2020. Rep. Adam Koenig expects to introduce another sports betting bill in Kentucky’s next legislative session, which begins Jan. 7, according to WDRB-TV. The bill would include mobile Bitcoin sports betting and would also legalize online poker. This next bill likely has […]
read moreNo One Is Falling For This Sports Betting Data Line

Andy Levinson, the senior VP of tournament administration for the PGA Tour, said recently data not provided by the PGA Tour to sportsbooks is “stolen data.” This latest salvo is one instance in the ongoing sports leagues’ battle for additional compensation from sports betting. What began as a search for integrity fees, quickly transitioned into […]
read morePA Sports Betting Handle Surges Behind Mobile Expansion

Pennsylvania sports betting topped September’s handle record in October easily, in large part thanks to another strong performance by FanDuel Sportsbook. Sportsbooks handled $241.2 million in bets in October, up 24% from the previous record of $194.5 million set last month. Revenue hit $19.1 million, down 1.1% from September. October had a win percentage of […]
read moreWhy CA Tribes Think Online Sports Betting Could Ruin What They’ve Built

California tribes filed a proposed ballot initiative Wednesday to amend the state constitution to allow for sports betting at Indian gaming casinos and licensed racetracks. The effort from a powerful coalition of 18 Native American tribes leaves out the state’s cardrooms isn’t surprising given the longtime animosity between the state’s two main gaming stakeholders. But […]
read moreOhio governor wants legislative action on sports betting

Unlike his neighbor to the north, Ohio Gov. Mike DeWine wants his state legislature to put a bill on his desk to legalize and regulate sports betting. He reasons that the demand is there for legal sports betting to come to the state in one way or another. He would prefer that it goes through […]
read moreFull House Resorts’ Indiana Sportsbook Partners Launch By Super Bowl?

Three more Indiana sportsbooks could launch online by the Super Bowl, according to Full House Resorts CEO Dan Lee, their casino partner in the state. At least two of them plan to launch Indiana sports betting by the end of this year: Smarkets and BetAmerica, the Churchill Down brand that runs on SBTech‘s platform. Smarkets, […]
read more
